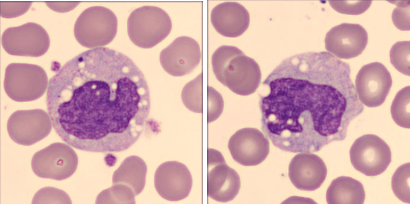
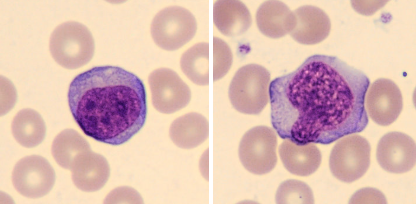

A diferenciação entre monócitos e linfócitos reativos em esfregaços sanguíneos pode ser um desafio considerável, especialmente para analistas clínicos com menor experiência. Embora essas células compartilhem algumas semelhanças morfológicas, elas desempenham funções distintas no sistema imunológico. Assim, a identificação precisa pode exigir uma análise mais atenta das características nucleares e citoplasmáticas, sempre correlacionada ao contexto clínico do paciente para garantir uma interpretação diagnóstica confiável.
MONÓCITOS
Os monócitos são as maiores células do sangue periférico e desempenham um papel fundamental no sistema imunológico. Eles representam entre 2% e 10% dos leucócitos circulantes em adultos saudáveis, além de serem precursores de macrófagos e células dendríticas nos tecidos, onde desempenham funções essenciais, como fagocitose de patógenos, apresentação de antígenos e remoção de detritos celulares.
Os monócitos destacam-se por seu tamanho, sendo geralmente maiores que os linfócitos reativos. O núcleo, de formato oval ou reniforme, é frequentemente excêntrico e apresenta cromatina frouxa com uma aparência reticulada distinta. O citoplasma é abundante, de coloração azul-cinza, com vacuolização frequente e a presença de pequenos grânulos azurófilos, conferindo uma aparência finamente granular.
Monócitos em esfregaço sanguíneo.
LINFÓCITOS REATIVOS
Os linfócitos reativos são linfócitos que apresentam alterações morfológicas em resposta a estímulos imunológicos, particularmente durante processos infecciosos ou inflamatórios, como infecções virais. Essas alterações refletem a ativação funcional dessas células em um contexto de resposta imunológica ativa.
Essas células frequentemente apresentam um tamanho aumentado em relação aos linfócitos normais, com um núcleo que pode ser oval, arredondado ou até irregular. A cromatina, embora mais densa do que a dos monócitos, é menos condensada do que a dos linfócitos normais, e nucléolos podem estar presentes em alguns casos. O citoplasma é mais abundante que os linfócitos normais, com basofilia mais ou menos intensa, podendo exibir vacúolos e bordas difusas que frequentemente acompanham o contorno de células adjacentes, como hemácias.
Linfócitos reativos em esfregaço sanguíneo.

O próximo passo de todo analista que deseja ter mais segurança na bancada
Todo analista que busca se destacar e se tornar um profissional mais atualizado, capacitado e qualificado para o mercado de trabalho precisa considerar uma pós-graduação. Isso porque, um profissional com especialização é valorizado na área laboratorial; esse é um fato inegável.
Por isso, unimos o útil ao agradável ao desenvolver uma pós-graduação em Hematologia Laboratorial e Clínica para aqueles que procuram a comodidade de uma pós-graduação 100% online e ao vivo, sem abrir mão da excelência no ensino.
Além disso, contamos com um corpo docente altamente qualificado, composto pelos melhores professores do Brasil, referências em suas áreas de atuação. Nossa metodologia, que combina teoria e prática da rotina laboratorial, garante um aprendizado efetivo e de qualidade.
No Instituto Nacional de Medicina Laboratorial, temos apenas um objetivo: mais do que ensinar, vamos tornar VOCÊ uma referência.
Toque no botão abaixo e conheça a pós-graduação em Hematologia Laboratorial e Clínica.
Referências:
BAIN, B. J. Células sanguíneas : um guia prático [recurso eletrônico] / Barbara J. Bain ; [tradução: Renato Failace]. – 5. ed. – Porto Alegre : Artmed, 2016.
DA SILVEIRA, Cristina Magalhães. Laboratório de Hematologia–teorias, técnicas e atlas. Editora Rubio, 2020.
DA SILVA, Paulo Henrique et al. Hematologia laboratorial: teoria e procedimentos. Artmed Editora, 2015.

